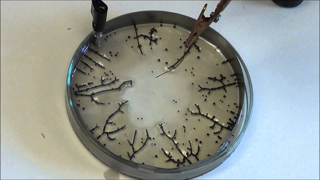
Self-Assembling Wires

Graphene Oxide In Covid Vaccine Under Microscope | German Video Reveals Self-Assembling Structures
watchman4u
Published on Aug 25, 2021
Graphene Oxide In Covid Vaccine Under Microscope | German Video Reveals Self-Assembling Structures
- Your Subscription
 watchman4u -
watchman4u -
Share Video
Add to
Flag Video
Rate video
Rate video
DISCLAIMER
The content presented in this stream and/or video may be satirical in nature for entertainment purposes. It may contain realistic scenarios that may include themes of racism, anti-semitism, anti-LGBT sentiment and even elements such as death threats, all purely in the context of parody. In addition, this content may depict or refer to acts of violence in a satirical manner. Shock factor is a common and deliberate element used in these displays to emphasise the satirical message. By continuing to view this content, you acknowledge that you understand the satirical nature of this content, including the depiction of violence and the use of shock factor, and agree that you will not use or interpret this content outside of its intended context. Please remember that humour and satire are complex; they are not intended to belittle or demean, but to engage and challenge social norms through exaggeration. If you have any concerns about content, please feel free to engage in constructive dialogue or report issues to GTV staff.
Up next
Recommended
-
Watch Later
 00:01
00:01Dr. Richard Fleming: Pfizer Vaccine Causes Blood Clots Under Microscope
833 views 1589 days ago -
Watch Later
 00:01
00:01SHOCKING: White Embalmer Clots Are Self Assembling Circuits
369 views 1289 days ago -
Watch Later
 00:01
00:01More on UNKNOWN ELEMENTS found in the 'SEALED' COVID VAX VIAL under LIGHT MICROSCOPE
506 views 1612 days ago -
Watch Later
![Spectroscopy Analysis Reveals 99.5% Graphene Oxide In Moderna Vaccination Vial]() 00:01
00:01Spectroscopy Analysis Reveals 99.5% Graphene Oxide In Moderna Vaccination Vial
1.5K views 1646 days ago -
Watch Later
![Dr Carrie Madej Discovers More Under The Microscope - 10/20/2021 - Stew Peters]() 00:01
00:01Dr Carrie Madej Discovers More Under The Microscope - 10/20/2021 - Stew Peters
1.1K views 1594 days ago